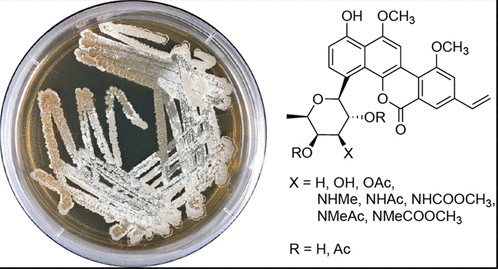
Ravidomycin analogs from Streptomyces sp. exhibit altered antimicrobial and cytotoxic selectivity

Publications
Chemical inhibition of a bacterial immune system
Zang, Z., Duncan, O.K., Sabonis, D., Shi, Y., Miraj, G., Fedorova, I., Le, S., Deng. J., Zhu, Y., Cai, Y., Zhang, C., Arya, G., Duerkop, B.A., Liang, H., Bondy-Denomy, N., Ve, T., Tamulaitiene., Gerdt, J.P. preprint. 2025. DOI:10.1101/2025.02.20.638879
Streptomyces secretes a siderophore that sensitizes competitor bacteria to phage infection
Zang, Z., Zhang, C., Park, K., Schwartz, D.A., Podicheti, R., Lennon, J.T., Gerdt, J.P. Nature Microbiology. 2025. DOI: 10.1038/s41564-024-01910-8
Chemical inhibition of cell surface modification sensitizes bacteria to phage infection
Addo, M.A., Zang, Z., Gerdt, J.P. RSC Chemical biology. 2024. DOI: 10.1039/d4cb00070f
Lipids from a snail host regulate the multicellular behavior of a predator of parasitic schistosomes
Kidner, R. Q., Goldstone, E. B., Laidemitt, M. R., Sanchez, M. C., Gerdt, C., Brokaw, L. P., Ros-Rocher, N., Morris, J., Davidson, W. S., Gerdt, J. P. iScience. 2024. DOI: 10.1016/j.isci.2024.110724
Exogenous lipid vesicles induce endocytosis-mediated cellular aggregation in a close unicellular relative of animals
Kidner, R. Q., Goldstone, E. B., Rodefeld, H. J., Brokaw, L. P., Gonzalez, A. M., Ros-Rocher, N., Gerdt, J. P. preprint

Host lipids regulate multicellular behavior of a predator of a human pathogen
Kidner, R. Q., Goldstone, E. B., Laidemitt, M. R., Sanchez, M. C., Gerdt, C., Brokaw, L. P., Ros-Rocher, N., Morris, J., Davidson, W. S.. Gerdt, J. P. preprint.

Bacterium secretes chemical inhibitor that sensitizes competitor to bacteriophage infection
Zang, Z., Zhang, C. Park, K. J., Schwartz, D. A., Podicheti, R., Lennon, J. T., Gerdt, J. P. preprint.
Interbacterial biofilm competition through a suite of secreted metabolites
Rayi, S., Cai, Y., Greenwich, J., Fuqua, C., Gerdt, J. P. ACS Chemical Biology. 2024. DOI: 10.1021/acschembio.3c00655
Ravidomycin analogs from Streptomyces sp. exhibit altered antimicrobial and cytotoxic selectivity
Park, KJ.; Maier, S.; Zhang, C.; Dixon, S.; Rusch, D.; Pupo, M.; Angus, S.; Gerdt, J. P. Journal of Natural Products. 2023. DOI: 10.1021/acs.jnatprod.3c00381
Chemical factors induce aggregative multicellularity in a close unicellular relative of animals
, , R.; , C.; , W.; , I.; 120 (18) e2216668120
A Metabolite Produced by Gut Microbes Represses Phage Infections in Vibrio cholerae
Zang, Z.; Park, K. J.; Gerdt, J. P. ACS Chem. Biol. 2022. 17, 9, 2396–2403.

Chemical Ecology of Choanoflagellates
Gerdt, J. P. “Chemical Ecology of Choanoflagellates,” In Comprehensive Natural Products III: Chemistry and Biology, Eds. Begley, T. P., Liu, H-W. 2019
Lysophosphatidylcholine regulates sexual stage differentiation in the human malaria parasite Plasmodium falciparum
Brancucci, N. M. B.*; Gerdt, J. P.*; Wang, C.; Niz, M. D.; Philip, N.; Adapa, S. R.; Zhang, M.; Hitz, E.; Niederwieser, I.; Boltryk, S. D.; Laffitte, M.-C.; Clark, M. A.; Grüring, C.; Ravel, D.; Soares, A. B.; Demas, A.; Bopp, S.; Rubio-Ruiz, B.; Conejo-Garcia, A.; Wirth, D. F.; Gendaszewska-Darmach, E.; Duraisingh, M. T.; Adams, J. H.; Voss, T. S.; Waters, A. P.; Jiang, R. H. Y.; Clardy, J.; Marti, M. “Lysophosphatidylcholine regulates sexual stage differentiation in the human malaria parasite Plasmodium falciparum” Cell 2017, 171:1532–1544.
Mating in the closest living relatives of animals is induced by a bacterial chondroitinase
Woznica, A.*; Gerdt, J. P.*; Hulett, R. E.; Clardy, J.; King, N. “Mating in the closest living relatives of animals is induced by a bacterial chondroitinase” Cell 2017, 170:1175–1183.
Chemical interrogation of LuxR-type quorum sensing receptors reveals new insights into receptor selectivity and the potential for interspecies bacterial signaling
Gerdt, J. P.*; Wittenwyler, D. M.*; Combs, J. B.; Boursier, M. E.; Brummond, J. W.; Xu, H.; Blackwell, H. E. “Chemical interrogation of LuxR-type quorum sensing receptors reveals new insights into receptor selectivity and the potential for interspecies bacterial signaling” ACS Chem. Biol. 2017, 12:2457–2464.
Unraveling the contributions of hydrogen-bonding interactions to the activity of native and non-native ligands in the quorum-sensing receptor LasR
Gerdt, J. P.*; McInnis, C. E.*; Schell, T. L.; Blackwell, H. E. “Unraveling the contributions of hydrogen-bonding interactions to the activity of native and non-native ligands in the quorum-sensing receptor LasR” Org. Biomol. Chem. 2015, 13:1453–1462.
Mutational analysis of the quorum-sensing receptor LasR reveals interactions that govern activation and inhibition by non-lactone ligands
Gerdt, J. P.*; McInnis, C. E.*; Schell, T. L.; Rossi, F. M.; Blackwell, H. E. “Mutational analysis of the quorum-sensing receptor LasR reveals interactions that govern activation and inhibition by non-lactone ligands” Chem. Biol. 2014, 21:1361–1369.
Competition studies reveal two major barriers that will preclude the spread of resistance to quorum-sensing inhibitors in bacteria
Gerdt, J. P.; Blackwell, H. E. “Competition studies reveal two major barriers that will preclude the spread of resistance to quorum-sensing inhibitors in bacteria” ACS Chem. Biol. 2014, 9:2291–2299.
Active efflux influences the potency of quorum sensing inhibitors in Pseudomonas aeruginosa
Moore, J. D.; Gerdt, J. P.; Eibergen, N. R.; Blackwell, H. E. “Active efflux influences the potency of quorum sensing inhibitors in Pseudomonas aeruginosa” ChemBioChem 2014, 15:435–442.
Controlling the direction of site-selectivity and regioselectivity in RNA ligation by Zn2+-dependent deoxyribozymes that use 2',3'-cyclic phosphate RNA substrates
Kost, D. M. *; Gerdt, J. P.*; Pradeepkumar, P. I.; Silverman, S. K. “Controlling the direction of site-selectivity and regioselectivity in RNA ligation by Zn 2+-dependent deoxyribozymes that use 2',3'-cyclic phosphate RNA substrates” Org. Biomol. Chem. 2008, 6:4391–4398.
Selective stabilization of natively folded RNA structure by DNA constraints
Gerdt, J. P.; Miduturu, C. V.; Silverman, S. K. “Selective stabilization of natively folded RNA structure by DNA constraints” J. Am. Chem. Soc. 2008, 130:14920–14921 .